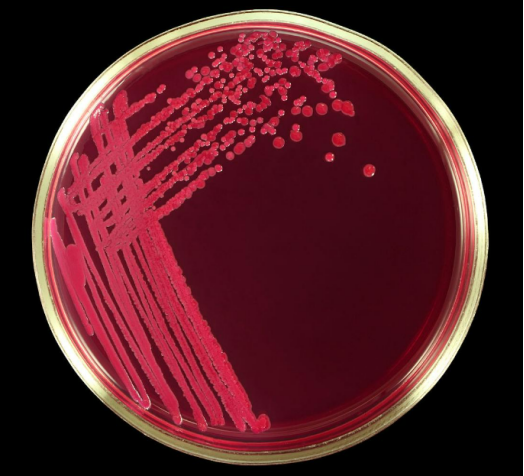

資訊中心
在《Angewandte Chemie 國(guó)際版》最近發(fā)表的一項(xiàng)研究中,卡羅林斯卡學(xué)院醫(yī)學(xué)生物化學(xué)和生物物理學(xué)系 (MBB) 的研究人員對(duì)圍繞輕元素碳、氫、氮和氧同位素的舊模式提出了質(zhì)疑。這些同位素現(xiàn)在的威力比人們想象的還要強(qiáng)大。
?
傳統(tǒng)上,科學(xué)家認(rèn)為生化反應(yīng)中的同位素效應(yīng)或多或少與同位素之間的質(zhì)量差成正比。例如,正常酶和超輕酶(重同位素13?C、2?H、15?N 和18?O 已耗盡的分子)之間 0.5% 的質(zhì)量差異應(yīng)產(chǎn)生不超過 1% 的動(dòng)力學(xué)效應(yīng)。然而,研究表明,效果可能達(dá)到 250%–300%,比預(yù)期大兩個(gè)數(shù)量級(jí),具體取決于溫度。
分子動(dòng)力學(xué)模擬廣泛應(yīng)用于數(shù)千種科學(xué)出版物,但一直忽視同位素組成。研究人員現(xiàn)在必須重新校準(zhǔn)他們的結(jié)果,考慮同位素的隱藏影響。
“同位素純化合物,例如酶,與傳統(tǒng)化合物相比具有優(yōu)越的特性。這不僅影響化學(xué)和生物化學(xué),還影響生物學(xué),可能還影響醫(yī)學(xué),”MBB 羅曼·祖巴列夫小組的教授兼研究組組長(zhǎng) Roman Zubarev 說。
科學(xué)技術(shù)的幾個(gè)領(lǐng)域可能會(huì)立即受到影響。“首先,超輕酶可以通過在同位素的培養(yǎng)基中生長(zhǎng)的大腸桿菌中來立即產(chǎn)生,正如我們?cè)谶@項(xiàng)工作中所做的那樣。這些酶的工作速度比相同的大腸桿菌表達(dá)的相應(yīng)酶快 2-3 倍,但可以生長(zhǎng)在普通媒體中。
?
“第二,超輕效應(yīng)在生物學(xué)中的應(yīng)用——人們可以培養(yǎng)超輕生物并研究它們的偏差特性。例如,我們?cè)诔p大腸桿菌上培養(yǎng)秀麗隱桿線蟲,發(fā)現(xiàn)它們生長(zhǎng)得更快,但衰老和死亡也更快。
“第三,同位素分離領(lǐng)域?qū)ο闹赝凰氐男枨蟠蠓黾印?赡苄枰_發(fā)包括色譜法在內(nèi)的新方法來滿足這一需求并降低超輕化合物的成本。
“最后,分析蛋白質(zhì)中穩(wěn)定同位素的技術(shù),例如我們的傅里葉變換同位素比質(zhì)譜法,將引起更大的興趣”。
?